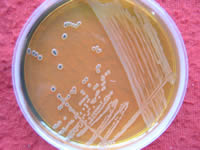

生物
-
类别:生物 发布时间:16-04-19 点击:1907
每天要一日三餐,定时定量,不挑食,不偏食,早餐吃好,中午吃饱,晚上吃少.合理膳食利于人体的健康成长,否则偏食等不合理的膳食习惯会导致营养不良或营养过剩.暴...
-
类别:生物 发布时间:16-04-19 点击:1625
1.ABD2.AB3.ABCE4.ABE5.ABCD其他类似问题问题1:植物学基础知识植物学基础中的主根和侧根为什么又叫定根[生物科目]植物学上把种子在萌发时由胚根突破种皮向下生长形...
-
类别:生物 发布时间:16-04-19 点击:2016
A、浮游动物是消费者,而食物链必须从生产者开始,故不正确;B、食物链的箭头指向消费者,把食物链的箭头反了,故不正确;C、D、浮游植物→浮游动物→植食性鱼→肉食...
-
类别:生物 发布时间:16-04-19 点击:2008
不是一样的啊.首先明确一点,“基因蓝图”是指遗传物质,主要是核DNA.然后要知道,所有体细胞的DNA是一样的,它们的生命蓝图一样.而在生殖细胞里面,次级精母细胞,次级卵...
-
类别:生物 发布时间:16-04-19 点击:1918
血清IgE升高是过敏性疾病最有力的提示.过敏原进入机体诱导产生特异性IgE,IgE结合到肥大细胞和嗜酸性粒细胞,使机体进入对该过敏原特异致敏状态,当过敏原再次接触时,与...
-
类别:生物 发布时间:16-04-19 点击:1653
这些书上都有呀.你没做笔记吗?你几班的认识一下.先帮你解决问题吧.1、在书上16~17页,2、在影响生物生存的生物因素中,同种生物之间的关系主要有互助和斗争;不同种生...
-
类别:生物 发布时间:16-04-19 点击:1962
决策学(ScienceofDesignMaking)以决策为研究对象的综合性学科.主要研究决策原理、决策程序和决策方法,探索如何作出正确决策的规律.是社会化大生产的直接产物,对于...
-
类别:生物 发布时间:16-04-19 点击:1575
(1)动物外表颜色与周围环境相类似,这种颜色叫保护色,利于动物避敌和捕食,是动物对生存环境的一种适应,是生物适应环境的表现.(2)虹膜中央有瞳孔,瞳孔的大小...
-
类别:生物 发布时间:16-04-19 点击:2008
药品分处方药和非处方药,非处方药是不需要医师处方、即可自行判断、购买和使用的药品,简称OTC.这些药物大都用于多发病常见病的自行诊治;处方药是必须凭执业医师...
-
类别:生物 发布时间:16-04-19 点击:1933
A、精神紧张时人体细胞代谢增强,产热增多,汗腺通过分泌汗液维持内环境体温相对稳定,A错误;B、此时甲状腺激素分泌增多,B错误;C、下丘脑体温调节中枢可控制汗腺...
-
类别:生物 发布时间:16-04-19 点击:1932
生物防治就是利用生物来防治病虫害.大致可以分为以虫治虫、以鸟治虫和以菌治虫三大类.它是降低杂草和害虫等有害生物种群密度的一种方法.它的最大优点是不污染环境...
-
类别:生物 发布时间:16-04-19 点击:2024
煮缩了的蚂蝗=-=,你别反胃啊……学名水蛭其他回答水生动物,具体无害,只是难看其他类似问题问题1:请问这是什么生物[政治科目]河豚问题2:这是什么生物[物理科目]这...
-
类别:生物 发布时间:16-04-19 点击:1859
(1)食物链是生产者和消费者之间由于食物关系而构成链条.它表示的是生产者和消费者之间的关系.其写法是:起点是生产者,依次是初级消费者、次级消费者、三级消费...
-
类别:生物 发布时间:16-04-19 点击:1584
(1)葡萄酒制作的原理是利用酵母菌分解葡萄糖生成丙酮酸,该物质在无氧条件下,转变成酒精.葡萄为酵母菌提供水、无机盐、碳源、氮源等生长繁殖必需的物质.(2)葡...
-
类别:生物 发布时间:16-04-19 点击:1855
1/3在a点,设有氧呼吸释放的二氧化碳为X,那么无氧呼吸释放的二氧化碳也是X.在有氧呼吸过程中,X摩尔的二氧化碳消耗了葡萄糖为X/6;而无氧呼吸过程中,X摩尔的二氧化碳消...
-
重组b_...F(负)细胞之间彼此能杂交重组B F(负)细胞必
类别:生物 发布时间:16-04-19 点击:1677F因子是供体大肠杆菌里存在的一种微小的质粒,质粒是染色体以外的环状DNA,能进行自我复制,所以C、D错.其实在大肠杆菌里有性别,含有F因子的菌称为F+,也叫供体;没有F因...
-
18周岁结婚_我国法定的结婚年龄是( )A.男不得早于18周
类别:生物 发布时间:16-04-19 点击:1652晚婚指的是提倡比法定结婚年龄晚2~3年结婚,法定结婚年龄是男不得早于22周岁,女不得早于20周岁.晚育是指提倡婚后推迟2-3年再生育.少生是指稳定一个低生育水平....
-
类别:生物 发布时间:16-04-19 点击:1636
一、“软着陆”是指国民经济的运行经过一段过度扩张之后,平稳地回落到适度增长区间.国民经济的运行是一个动态的过程,各年度间经济增长率的运动轨迹不是一条直线,而是...
-
类别:生物 发布时间:16-04-19 点击:1569
属于其他类似问题问题1:谁黄鹂鸟的叫声?要清晰一点的我要给我的鸟放,让它学你的鸟?你听听下面这个吧.问题2:黄鹂的叫声是什么去去就来,去去就来.问题3:黄莺的叫声...
-
类别:生物 发布时间:16-04-19 点击:1981
我本来是一楼的,但看了2楼的答案,我不得不出来纠正下,免得楼主选了个错误答案~2楼的错了!珠被发育成的是种皮,不是果皮.3楼是对的,部分植物的珠柄可发育成假种皮,可食...
-
类别:生物 发布时间:16-04-19 点击:1948
2003年,一块巨大怪肉被冲上智利蒙特港附近的海滩.怪肉长12米,重13吨,由于没有骨骼和器官,人们猜它是一种巨大动物遗骸的一部分.80年前,人们在美国佛罗里达州海滩也发...
-
类别:生物 发布时间:16-04-19 点击:1875
A、血浆渗透压感受器位于他丘脑中,当血浆渗透压升高时,他丘脑分泌的抗利尿激素增加,同时将兴奋传递给大脑,产生渴觉,A正确;B、诱捕雄虫可干扰昆虫的正常交尾,...
-
类别:生物 发布时间:16-04-19 点击:1738
主要有6点:1,目的酶即所需要的酶含量高;2繁殖快,生产周期短;3产酶性能稳定;4不易感染噬菌体;5原料廉价,容易培养和管理;6安全可靠即不是致病菌也不能产生毒素....
-
类别:生物 发布时间:16-04-19 点击:1902
一个氨基酸对应一个密码子(3个核苷酸)翻译这条肽链的mRNA含核苷酸=2332×3=6996基因(DNA双链)含核苷酸=6996×2=13992所以,第八因子基因是由13992个碱基对组成其...
-
类别:生物 发布时间:16-04-19 点击:1764
扬子鳄?金丝猴、大熊猫...
-
类别:生物 发布时间:16-04-19 点击:1898
大致可分为2个原因,1是没有记忆的习惯,2,随着年龄的增长大脑细胞死亡速度的加速,记忆东西的脑细胞的死亡而衰退可能你体会过为什么小时候记忆力强这个是因为小的时候,...
-
类别:生物 发布时间:16-04-19 点击:1727
生态系统具有自动调节恢复稳定状态的能力.生物种类的多少与生态系统的调节功能又有一定的关系.生态系统的结构越复杂,能量流动和物质循环的途径越多,其调节能力,...
-
消化_1.消化的种类包括( )和( ).2.胃壁有发达的( )层
类别:生物 发布时间:16-04-19 点击:18461.消化的种类包括(物理消化)和(化学消化).2.物理消化:胃壁有发达的(肌肉)层,收缩时引起胃的蠕动,可以(研磨)和(搅拌)食物.3.化学消化:对(复杂的营养物质...
-
文昌鱼是鱼吗_...但属于真正的鱼类的是( ) A.文昌鱼 B
类别:生物 发布时间:16-04-19 点击:1592D分析:本题考查鱼类的主要特征.鱼类的特征有生活在水中,鱼体表大都覆盖有鳞片,减少水的阻力,用鳃呼吸,用鳍游泳,靠尾部和躯干部的左右摆动和鳍的协调作用来不...
-
类别:生物 发布时间:16-04-19 点击:1545
环节动物是依靠湿润的体壁进行气体交换,节肢动物是依靠气管直接与组织细胞进行气体交换,气门是呼吸通道.鸟类家鸽进行气体交换的部位是肺,而气囊有储存气体的作用...
-
类别:生物 发布时间:16-04-19 点击:1517
2005年,英国《独立报》又披露了知名生物技术公司“孟山都”的一份报告,以转基因食品喂养的老鼠出现器官变异和血液成份改变的现象,澳大利亚联邦科学与工业研究组织发...
-
类别:生物 发布时间:16-04-19 点击:1705
其他回答这个你可以百度一下都能找到的追问:你百度一下发给我追答:自己动手追问:那你这不是废话吗?...
-
类别:生物 发布时间:16-04-19 点击:1684
2003年,一块巨大怪肉被冲上智利蒙特港附近的海滩.怪肉长12米,重13吨,由于没有骨骼和器官,人们猜它是一种巨大动物遗骸的一部分.80年前,人们在美国佛罗里达州海滩也发...
-
类别:生物 发布时间:16-04-19 点击:1666
生境:蝌蚪完全生活在水中,一般在池塘边的浅水区.而蛙则生活在池塘的浅水区、水田、沼泽地等地区.呼吸器官:蝌蚪靠鳃,蛙用皮肤与肺!四肢:蝌蚪发育前期无四肢,不同时...
-
类别:生物 发布时间:16-04-19 点击:1851
涂布过过程中不要将涂布棒使劲按在培养基上,要留一定的空隙,要将溶液涂开,而不是从一个地方推到另一个地方其他回答两边贴大概200UM的垫片,相对移动错开去涂。你们的...
-
类别:生物 发布时间:16-04-19 点击:1563
(1)火腿肠超过保质期容易变质,因此从安全角度考虑我们应关注包装说明上的生产日期和保质期;(2)发现包装已经膨胀的火腿肠,说明有细菌繁殖,食品变质腐败,不能...
-
类别:生物 发布时间:16-04-19 点击:1765
生态环境问题是指人类为其自身生存和发展,在利用和改造自然的过程中,对自然环境破坏和污染所产生的危害人类生存的各种负反馈效应;拟定保护生态环境的计划,应从水...
-
类别:生物 发布时间:16-04-19 点击:1777
B...
-
类别:生物 发布时间:16-04-19 点击:2013
是指某条DNA片段(单链双链都行)上的C和G这两种碱基的含量,DNA(单双链都行)或者RNA中鸟嘌呤(C)和胞嘧呤(G)其他回答DNA(单双链都行)或者RNA中鸟嘌呤(C)和...
-
类别:生物 发布时间:16-04-19 点击:1719
脊索动物门Chordata爬行纲Reptilia有鳞目Squamata蜥蜴亚目Lacertilia蜥蜴是一个目类,它包括很多属和科石龙子俗称四脚蛇,属于蜥蜴亚目下的石龙子属,石龙子科,其下的品...
-
类别:生物 发布时间:16-04-19 点击:1589
(1)蜜蜂在发现蜜源以后,就会用特别的“舞蹈”方式(如“8”字形摆尾舞),向同伴通报蜜源的距离远近和方向.油菜花靠昆虫传粉叫虫媒花.虫媒花有适合昆虫传粉的结...
-
类别:生物 发布时间:16-04-19 点击:1772
A、先天性畸形是遗传病,因此亲属中生过先天性畸形孩子的待婚青年需要进行遗传咨询,A正确;B、肝炎是传染病不是遗传病,因此得过肝炎的夫妇不需要进行遗传咨询,B不...
-
类别:生物 发布时间:16-04-19 点击:1840
(1)细胞??(2)种群????(3)生物圈...
-
类别:生物 发布时间:16-04-19 点击:1657
录像机录像机因为鹿像鸡所以大家都说鹿和鸡是亲戚咯其他类似问题问题1:动物园动物类英语单词越多越好,如:liontigerpeacock[语文科目]horse马mare母马colt,foal马驹...
-
2007年诺贝尔奖_...?重庆)小鼠基因敲除技术获得2007
类别:生物 发布时间:16-04-19 点击:1585(1)作为质粒的一个条件之一就是要具有标记基因,以检测外源基因是否导入受体细胞.癌变的产生就是原癌基因由抑制态变激活态.(2)如果抑癌基因被敲除,原癌基因被...
-
类别:生物 发布时间:16-04-19 点击:1836
(1)分析题图甲及题中信息,4是终止密码子,当1和2形成的复合物可辅助终止密码子发挥作用,可推测是使翻译过程停止,翻译的场所是核糖体.(2)从图乙上看,朊病毒...
-
类别:生物 发布时间:16-04-19 点击:1936
(1)根据题意,甜玉米的性状由基因d控制,且基因e对d起增强作用,所以普通玉米的基因为显性基因.(2)根据题意,若d和e基因独立遗传,既遵循自由组合定律,则DdEe...
-
类别:生物 发布时间:16-04-19 点击:1779
减少(Reduction)、优化(Refinement)和替代(Replacement),统称3R.具体而言,“减少”就是尽可能地减少实验中所用动物的数量,提高实验动物的利用率和实验的精确度...
-
类别:生物 发布时间:16-04-19 点击:1626
D一般说来,排泄尿酸是卵生动物的特点,排泄尿素是胎生动物的特点.值得注意的是,软体动物、昆虫等无脊椎动物和爬行类、鸟类等脊椎动物在进化系统中属于早已分开的2个支...
-
类别:生物 发布时间:16-04-19 点击:1977
其他回答那是美食会的GT机器人,控制者是美食会的副料理长斯塔久。...
-
类别:生物 发布时间:16-04-19 点击:1509
鳌虾的体表有较硬的甲,属于甲壳动物,生活在水中,用鳃呼吸.故选:A...
-
n10_今有一化合物,其分子式为C55H70O19N10,已知将它
类别:生物 发布时间:16-04-19 点击:2018答案:10,9,4,3.分析如下:四种氨基酸,每个氨基酸只含有一个—NH2,谷氨酸含有二个-COOH,其他氨基酸只含有1个.一个肽上至少有一个游离-NH2和一个游离的-COOH再根据分...
-
类别:生物 发布时间:16-04-19 点击:1701
A...
-
类别:生物 发布时间:16-04-19 点击:1534
LB液体培养基:蛋白胨10g/L,酵母提取物5g/L,NaCl10g/L,pH调至7.0固体:在LB液体培养基的条件下加入15g/L琼脂粉YPD或YPED,:YeastExtractPeptoneDextroseMedium(1L),...
-
类别:生物 发布时间:16-04-19 点击:1654
那个叫“linaze”的回答是试验相关必需品,非常完善.现在说一下代替相关的:试管,只要有帽或塞子都可以.移液管比移液枪要好用得多,而且可以重复利用.烘箱改成培养箱,...
-
类别:生物 发布时间:16-04-19 点击:1874
操作步骤:取鲜猪脾,去脂、血,称取10g,用预冷的1×SSC溶液洗2次,剪碎.按睥:1×SSC=1;5W/V加入50ml预冷的1×SSC,用高速组织捣碎机破碎8次,每次5秒,中间间隔30秒.将匀...
-
类别:生物 发布时间:16-04-19 点击:2016
抗体酶是具有酶活性的抗体.底物和酶的活性中心结合时底物发生构象改变,产生过渡态.如果将底物的过渡态类似物作为抗原,注入动物体内产生抗体,则抗体在结构上与过渡态...
-
类别:生物 发布时间:16-04-19 点击:1772
白细胞有五种:分别是,淋巴细胞,单核细胞,嗜中性粒细胞,嗜酸性细胞,嗜碱性细胞;由于测量的原理和精确度不同,三分类仪器只能按大小把这五类细胞分成三个分群:淋巴细...
-
类别:生物 发布时间:16-04-19 点击:1692
细胞膜,红色色素在液泡中的细胞液中,要出来必须经过液泡膜,细胞膜.其他类似问题问题1:将红苋菜在沸水煮几分钟,水变红了,是破坏了细胞的什么结构[生物科目]细胞膜,加...
-
类别:生物 发布时间:16-04-19 点击:1975
白风暴:白风暴中盐尘的主要来源一是开垦的耕地及其周围地区因次生盐碱化而在地表和土壤中积累的盐分;二是湖面缩减露出的湖底部分所含的盐分.附:20世纪60年代中亚...
-
硝酸甘油用法_硝酸甘油(C3H5N3O9)在医药上用作血管扩
类别:生物 发布时间:16-04-19 点击:1679硝酸甘油被吸收时,需要穿过口腔上皮细胞(2层细胞膜),毛细血管壁(2层细胞膜)进入血液,到达心脏血管壁外的平滑肌细胞时要出毛细血管壁(2层细胞膜)进入组织液...
-
类别:生物 发布时间:16-04-19 点击:1514
液泡里其他类似问题问题1:北京香山的红叶呈现红色,是因为叶肉细胞中有较多的花青素的缘故,这种物质存在于细胞的()A.细胞壁B.细胞质C.液泡D.细胞核[生物科目]正...
-
类别:生物 发布时间:16-04-19 点击:1941
(1)病原体是指引起传染病的细菌、病毒和寄生虫等生物.如肝炎病毒、痢疾杆菌、蛔虫等均属于病原体.因此,蛔虫是引起蛔虫病的病原体.(2)传染病的预防措施有三个...
-
鲍鱼b_鲍鱼属于( )A.鱼类B.软体动物C.环节动物D.扁形
类别:生物 发布时间:16-04-19 点击:1895软体动物的形态结构差异较大,种类繁多,约10万多种;但基本结构是相同的:用鳃呼吸,身体柔软,具有坚硬的贝壳,身体藏在壳中,藉以获得保护,由于贝壳会妨碍活动,...
-
类别:生物 发布时间:16-04-19 点击:1671
A、这个草原生态系统共有四种生物,通过这四种生物中所含的能量分析,它们之间的食物关系是比较明显的,即兔吃草,而狼、狐吃兔,同时狼吃狐,所以兔属于初级消费者...
-
类别:生物 发布时间:16-04-19 点击:1692
学习行为是指在遗传因素的基础上,通过环境因素的作用,由生活经验和学习而获得的行为.动物越聪明,学习能力越强,适应环境能力也就越强.不同动物“尝试与错误”的...
-
类别:生物 发布时间:16-04-19 点击:1948
扬子鳄或称作鼍,是中国特有的一种鳄鱼,是世界上体型最细小的鳄鱼品种之一.它既是古老的,又是现在生存数量非常稀少、世界上濒临灭绝的爬行动物.在扬子鳄身上,至...
-
类别:生物 发布时间:16-04-19 点击:1764
目前关于引起气候变化的原因有几种说法,主要有两种说法:1、大气候条件.我们都知道,目前,我们的地球正在逐渐变暖,而又科学家认为,这种变暖是地球自身调节的“规律”....
-
abo系统血型有几种_ABO血型系统的血型分为___、___、_
类别:生物 发布时间:16-04-19 点击:1668ABO血型系统包括:A型、B型、AB型、O型四种血型;输血时必须注意血型的选择,应该以输入同型血为原则.如果血型不合,红细胞会发生凝集成团的现象,阻碍血液循环,引...
-
类别:生物 发布时间:16-04-19 点击:2004
其他回答蠼螋,俗称甲板虫...
-
类别:生物 发布时间:16-04-19 点击:1770
长江流域_______________中华鲟(AclpenserSinensisGrdy)是一种大型的溯河洄游性鱼类,是我国特有的古老珍稀鱼类.世界现存鱼类中最原始的种类之一.远在公元前1千多年的...
-
类别:生物 发布时间:16-04-19 点击:1509
实验是要检测环境因素对金鱼藻光合作用的影响,实验主要通过瓶内气体体积变化推动有色溶液带来的刻度变化判断金鱼藻光合作用的强度,因此必须排除自然状况下(如热胀冷...
-
简阳天气2345_(2014?简阳市模拟)目前,我国北方地区
类别:生物 发布时间:16-04-19 点击:1765A、雾霾天气自然因素有:大气空气气压低,空气不流动,使空气中的微小颗粒聚集,漂浮在空气中.2、地面灰尘大,空气湿度低,地面的人和车流使灰尘搅动起来,A正确;B...
-
类别:生物 发布时间:16-04-19 点击:1881
日本正在研制的用高分子聚碳酸酯与液晶结合而成的液晶膜或人工分离膜已在医药工业得到应用.比如,在医疗中,将薄膜做成胶囊状,把消炎剂放人里面,然后将胶囊埋入发炎部...
-
类别:生物 发布时间:16-04-19 点击:1677
(1)病毒是一类结构十分简单的微生物,它没有细胞结构,主要有蛋白质的外壳和内部的遗传物质组成.病毒是寄生在其它生物体的活细胞内,依靠吸取活细胞内的营养物质...
-
类别:生物 发布时间:16-04-19 点击:1805
新发现的蓝种人长期适应了高山生活,他们生活在高海拔山区,空气稀薄,氧含量只有海平面的二分之一,这是个终年积雪不化的冰雪世界,常年气温在零下四五十度.为获取足够的...
-
类别:生物 发布时间:16-04-19 点击:2013
A、一株玉米是一个植物体;B、月季花属于器官;C、血液属于结缔组织;D、胃属于器官.故选C...
-
类别:生物 发布时间:16-04-19 点击:2007
白燕和血燕中的营养成份平均含量营养成份白燕血燕水分(%)9.258.67粗灰分(%)8.2211.43粗蛋白质(%)58.6256.34总醣(%)24.6222.75热量(千卡/100克)440404蛋白质的生理功...
-
类别:生物 发布时间:16-04-19 点击:1986
其他回答知识与技能参与调查动物在人们生活中的作用举例说出现代化生物科学技术——生物反应器、仿生在人类生活和社会发展中的作用。情感态度与价值观关注科学、技术...
-
类别:生物 发布时间:16-04-19 点击:1941
其他回答最好能传图片来看看...
-
类别:生物 发布时间:16-04-19 点击:1501
地球上最早的原始生命诞生于原始海洋.那时的原始大气中有CH4、NH3、H2O、H2以及H2S和HCN等多种气体,但没有氧气存在,是一种还原性大气.在多分子体系演变为原始生...
-
类别:生物 发布时间:16-04-19 点击:1740
上皮细胞培养1)表皮细胞培养1.取材:取外科植皮或手术残余皮肤小块,以角化层薄者为佳,早产流产儿皮肤更好,切成0.5~1平方厘米小块.2.EDTA处理:先置入0.02%EDTA中室...
-
类别:生物 发布时间:16-04-19 点击:1679
A、大脑皮层有调节反射的高级中枢,但不在脑的后部,A错误;B、小脑有维持平衡、协调运动的功能,受损后不会死亡,B错误;C、脑干中有与呼吸、心跳有关的基本生命中...
-
类别:生物 发布时间:16-04-19 点击:1577
D...
-
类别:生物 发布时间:16-04-19 点击:1688
绿色植物通过光合作用吸收二氧化碳,释放氧气;呼吸作用吸收氧气,释放二氧化碳,这样就使的生物圈中的氧气和二氧化碳的浓度处于相对的平衡状态,简称碳-氧平衡.由...
-
类别:生物 发布时间:16-04-19 点击:1766
A、脑包括大脑、小脑和脑干,其中小脑能使运动协调,准确,维持身体平衡.不符合题意.B、线粒体是呼吸作用的场所,在线粒体里分解有机物释放能量,供身体活动利用....
-
类别:生物 发布时间:16-04-19 点击:1538
首先我们明确“白色汁液”是植物制造的有机物.又知筛管是植物韧皮部内输导叶子光合作用制造的有机养料的管道.由许多管状活细胞上下连接而成.相邻两细胞的横壁上有...
-
类别:生物 发布时间:16-04-19 点击:1739
冷血动物又称变温动物,地球上的动物大部分都是变温动物.变温动物并不是需要寒冷,而是其体温与其所生活的环境相适应,如鱼、蛙、蛇、变色龙等.变温动物的体温是随着环...
-
类别:生物 发布时间:16-04-19 点击:1898
C:生物性因素其他类似问题问题1:致病的因素都有哪几个因素?大类分物理,化学,生物致病因素.物理:辐射等;化学:有毒有害试剂等;生物:病菌,病毒等.问题2:还有元...
-
类别:生物 发布时间:16-04-19 点击:1751
抗体滴度应该是指抗体中和病毒或毒素等抗原的能力,由于抗体滴度是等比关系,一般使用几何平均数求平均值来衡量这一指标.计算方法根据样本量有所不同,详细看这里:希望...
-
类别:生物 发布时间:16-04-19 点击:1829
珊瑚虫只有水螅型的个体,呈中空的圆柱形,下端附着在物体的表面上,顶端有口,围以一全圈或多圈触手.触手用以收集食物,可作一定程度的伸展,上有特化的细胞(刺细胞),刺...
-
类别:生物 发布时间:16-04-19 点击:1589
扦插一般是指把植物的茎进行切断,经过处理之后,插在土壤中,然后每一段枝条都可以生根发芽,长出一个新的植株.此生殖过程中无精子、卵细胞的结合过程,属于无性繁...
-
类别:生物 发布时间:16-04-19 点击:1937
A、斑马在草原上成群活动是集群分布,故A错误;B、每毫升河水中有9个大肠杆菌是指种群密度,为种群的数量特征,不属于种群空间特征,故B正确;C、稗草在稻田中随机分...
-
类别:生物 发布时间:16-04-19 点击:1720
一个氨基酸对应一个密码子(3个核苷酸)翻译这条肽链的mRNA含核苷酸=2332×3=6996基因(DNA双链)含核苷酸=6996×2=13992所以,第八因子基因是由13992个碱基对组成其...
-
类别:生物 发布时间:16-04-19 点击:1816
(1)鸟类的体温约为40℃,要想孵化鸡卵,必须提供和鸟类体温相同的孵化环境.(2)如果要说明创口对实验结果没有影响,变量应为“是否有创口”,此时丙组与丁组为对...
-
类别:生物 发布时间:16-04-19 点击:2019
一、1.B2.D3.D4.B5.B二、1.ABD2.AB3.BCE4.ABC5.ABCD三、1.×2.×3.√4.√5.×...
-
类别:生物 发布时间:16-04-19 点击:1582
其他回答追答:这不是吗...
-
类别:生物 发布时间:16-04-19 点击:1904
叶片的结构包括:表皮、叶肉、叶脉三部分.表皮分为上表皮和下表皮,叶肉包括栅栏组织和海绵组织,栅栏组织靠近上表皮,因为表皮无色透明,能直接接受到阳光的照射,...
-
类别:生物 发布时间:16-04-19 点击:1682
生物越多样,群落结构就越复杂,生态系统就越稳定.其他回答生物多样性使生命在这个行星上变得可能。没有生物多样性,你也不能在这个行...生物多样性之网已经开始土崩瓦...
-
类别:生物 发布时间:16-04-19 点击:1590
A、消灭蚊虫属于切断传播途径,不是控制传染源,A错误;B、消灭蚊虫属于切断传播途径,B正确;C、消灭蚊虫属于切断传播途径,不是保护易感人群,C错误;D、消灭蚊虫...